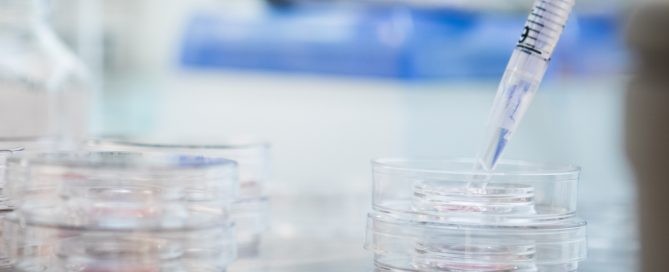
Hur många äggblåsor är normalt vid IVF?

Vår kunskapsbank
Varför fäster inte ägget i livmodern?
Embryots utveckling När ett ägg har blivit befruktat bildar det två kärnor, en från spermien och en från ägget. Dessa smälter sedan ihop och bildar en gemensam kärna – den nya individens kärna, med DNA från både föräldrarna. Det befruktade ägget förbereder sig för sin första delning som sker ungefär ett dygn efter att [...]
Äggmognadsspruta biverkningar
Olikkönade och samkönade kvinnliga par samt ensamstående kvinnor som har en barnönskan, kan välja IVF som behandlingsmetod för att få chans att bli föräldrar/förälder. IVF kallas också provrörsbefruktning och innebär att ägg befruktas utanför kroppen med mannens eller donerade spermier. Efter det återförs ett befruktat ägg in i livmodern. Det finns också andra typer [...]
Symtom efter embryoåterföring
Embryoåterföring är en del i IVF-behandlingen, och innebär att det embryo som visar sig ha högst kvalitet väljs ut för att återföras till livmodern. Det hela sker genom att embryot dras upp i en tunn slang (även kallat kateter), som av IVF-läkaren förs in i livmoderhålan där embryot placeras. En liten droppe näringsvätska följer [...]
Att tänka på efter återföring av embryo
Vid en IVF-behandling tas ägg ut från äggstockarna genom att en IVF-läkare punkterar äggblåsorna med en nål, och vätskan innehållande ägget förs över till ett provrör. Äggen tas om hand av embryologerna som sammanför äggen med spermier senare samma dag. Efter några dagar återförs det befruktade ägget (även kallat embryot), till livmodern där det [...]
Hur många äggblåsor är normalt vid IVF?
Alla individer har olika fysiska förutsättningar och det gäller även när det kommer till äggstockarnas förmåga att utveckla mogna ägg. Utvecklingen sker genom påverkan av hormoner, antingen naturligt inför en ägglossning, eller i samband med hormonstimulering (även kallat hormonbehandling) vid exempelvis en IVF-behandling. Det som gör att olika personer reagerar olika på hormonerna är [...]
Hur många ägg är normalt vid IVF?
När en kvinna genomgår en hormonbehandling i samband med IVF, varierar det mycket från individ till individ hur äggstockarna reagerar på hormonet. Det är ett brett spann, från att vissa kvinnor har äggstockar som reagerar starkt på små doser, till att andra kvinnor kan ha en svag reaktion vid höga doser. [...]
IVF, blödning innan testdag
IVF är en behandling vid infertilitet. IVF-behandlingen går i korta drag ut på att kvinnan genomgår en hormonstimulering, även kallat hormonbehandling, och därefter tas de ägg som utvecklats i äggstockarna ut av en IVF-läkare. Dessa befruktas med spermier i ett IVF-lab, och efter några dagar återförs ett befruktat ägg till livmodern. Det är mycket [...]
Träning under IVF-behandling
Fysisk aktivitet Att röra på sig, både regelbundet i vardagen och genom träning, är viktigt för att kroppen ska fungera på ett bra sätt. Hormoner i kroppen påverkas av både av över- och undervikt hos kvinnan, och det kan ibland hos vissa vara något som påverkar chansen att bli gravid. När man försöker bli [...]
När fäster embryot vid IVF?
IVF (även kallat provrörsbefruktning) innebär att ägg och spermier möts utanför kroppen, i ett IVF-laboratorium. Om ägget blir befruktat odlas det några dagar och under dessa dagar följer embryologerna som jobbar i labbet, embryots utveckling. Dagen efter att spermier och ägg sammanförts ser man två kärnor i ägget, en som är från ägget och [...]
Chans att lyckas med blastocyst
IVF, en behandling för ofrivilligt barnlösa, har funnits i Sverige sedan 80-talet. Tillvägagångsättet har förändrats på många sätt och metoden har utvecklats till att bli både bättre och säkrare. Nya tekniker inom IVF sedan 80-talet är exempelvis att man kan injicera spermier i ett ägg, (ICSI, intracytoplasmisk spermie injektion), att [...]
Hormoner för att bli gravid
Kvinnans menstruationscykel hänger ihop med naturliga variationer av hormonnivåer i kroppen. Dagarna runt ägglossningen är chansen som störst att bli gravid. För att hitta de dagarna är det bra att använda ägglossningstest, som finns att köpa på apotek eller i matvarubutiker. För kvinnor som har regelbundna cykler på ca 28 dagar brukar ägglossningen infalla [...]
IVF-behandling – biverkningar
IVF är en fertilitetsbehandling (även kallat provrörsbefruktning), där ägg befruktas med spermier utanför kroppen. Det är en vanlig metod för de par som är ofrivilligt barnlösa. För att kunna optimera behandlingen vill man ha fler än ett ägg att befrukta. Därför genomgår kvinnan en hormonstimulering där målet är att få ungefär tio ägg som [...]
Åldersgräns insemination Sverige
Insemination är en fertilitetsbehandling (även kallat assisterad befruktning) som innebär att spermier förs in i livmodern i samband med ägglossning. Spermierna tar sig sedan själva mot ägget som kommer från äggstocken genom äggledaren. Befruktning sker i äggledaren och efter några dagar implanterar det befruktade ägget förhoppningsvis i livmoderns slemhinna. Insemination utförs på IVF-kliniker i [...]
Spermiedonation ensamstående – så funkar det
Ensamstående kvinnor har sedan 1 april 2016 samma rättigheter till assisterad befruktning som ett heterosexuellt eller lesbiskt par. Detta innebär att de kvinnor som tidigare åkt till exempelvis Danmark för att göra behandling har möjlighet att göra det i Sverige istället. Privatkliniker har tidigare bara fått utföra insemination med donerade spermier, medan universitetsklinikerna fått [...]
Gravid med IVF
För att kunna påbörja en IVF-behandling behöver den ansvariga IVF-läkaren information om patienten/patientparet angående eventuella bakomliggande orsaker till infertiliteten. Den informationen kommer från fertilitetsutredningen som patienten/paret genomgår innan det är dags att välja behandlingsalternativ. Under utredningen tar man också ett blodprov som visar hur äggreserven ser ut hos kvinnan, det vill säga hur många [...]
IVF efter 40
Det är vanligt att många väntar med att försöka skaffa barn tills att det känns som att rätt tid i livet infinner sig. Kanske vill man satsa på sin karriär, kanske man vill ha en viss ekonomisk stabilitet, eller kanske vill man ha ägnat sig åt resande till exempel. En vanlig anledning till att [...]
Överstimulering IVF-behandling
Vid IVF (provrörsbefruktning) tas ägg ut från äggstockarna för att befruktas med spermier utanför kroppen i ett IVF-laboratorium. För att optimera chanserna att kunna återföra ett befruktat ägg (embryo), med hög kvalitet, till livmodern brukar kvinnan oftast få genomgå en hormonstimulering, för att få flera ägg att mogna. I den naturliga menstruationscykeln är det [...]
IVF syskonförsök kostnad
Alla landsting i Sverige finansierar att antal IVF-behandlingar eller inseminationer för varje patient/patientpar om landstingets kriterier är uppfyllda, men finansieringen gäller bara för patientens/parets första gemensamma barn. Om patienten/paret önskar göra en syskonbehandling behöver de därför vända sig till en privatklinik. Det finns privata kliniker på flera orter i Sverige, exempelvis Stockholm, Göteborg och [...]
Insemination Sverige – regler
Insemination är en fertilitetsbehandling som innebär att spermier förs in i livmodern i samband med ägglossning. Spermierna kan antingen vara från den blivande pappan, eller från en spermadonator. Insemination med donerade spermier I Sverige har det sedan länge varit tillåtet med insemination med donerade spermier för heterosexuella par där mannen saknar egna spermier. Från [...]
IVF steg för steg
IVF är en metod för att hjälpa de par som har svårt att bli gravida på egen hand. Efter att ha försökt i ett år utan att lyckas kan paret söka hjälp inom sjukvården, att få göra en fertilitetsutredning. . Om kvinnan är äldre än 35 år kan utredning startas redan efter ett halvårs [...]
IVF tvillingar
Tidigare har behandling med IVF (provrörsbefruktning) varit förenat med hög risk för tvillingar och trillingar. Men sedan slutet av 1990-talet började resultaten gällande födda barn efter behandling med IVF förändras på ett positivt sätt. Andelen födda tvillingar och trillingar sjönk, och andelen födslar med bara ett barn ökade. Detta berodde på att metoden för [...]
Vad kostar provrörsbefruktning i Sverige?
IVF (provrörsbefruktning) och andra typer av fertilitetsbehandlingar kan finansieras på olika sätt. Vissa par/patienter får remiss till reproduktionsmedicinska centra på sjukhus för behandling, vilket bekostas helt av landstinget, och vissa betalar själva (privat) för sin behandling. Landstinget För landstingsfinansierad behandling gäller att paret/patienten ska uppfylla de kriterier som ställs av landstinget, vilket handlar om [...]
Hur många lyckas med IVF första gången?
Att genomgå IVF är för de flesta en speciell tid och många upplever det som en berg-och-dalbana. Det kan vara påfrestande både känslosamt och fysiskt för båda parter och man brottas kanske med många frågeställningar gällande livet i stort men även gällande behandlingen i sig. Det är många som väljer att inte berätta för [...]
IVF Väntetid
IVF är en metod för att hjälpa de som inte kan bli gravida på egen hand, och den utförs på ett antal kliniker i landet, både privata och på sjukhus. På sjukhusen och vissa privatkliniker som har avtal med landstinget kan patienter som uppfyller landstingets kriterier få upp till tre behandlingar utan kostnad. Man [...]
IVF efter missfall
Missfall är vanligt bland alla som försöker få ett barn, både på naturlig väg och genom en fertilitetsbehandling. Av alla graviditeter som är konstaterade, avstannar ungefär 20 %. Det sker oftast i ett tidigt stadium, dvs före graviditetsvecka 12. Det finns många olika anledningar till att det blir missfall, men den absolut vanligaste är [...]
Vill du bli kontaktad gällande utredning & behandling vid ofrivillig barnlöshet?
[contact-form-7 id=”2616″ title=”Kontaktformulär 1″]